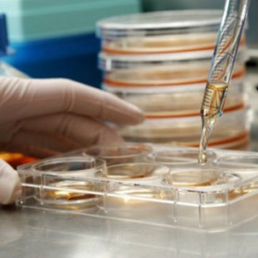

Il senato ha approvato, con 259 si e 6 no, il provvedimento, “Disposizioni urgenti in materia sanitaria”, firmato dall’ex ministro della Salute Renato Balduzzi: il decreto sulle staminali è, dunque, diventato legge.
È stato previsto che chi ha già iniziato le terapie con il metodo Stamina (infusione di cellule staminali adulte nei piccoli pazienti) può continuarle «sotto la responsabilità del medico prescrittore», ed è stato previsto l’avvio di una sperimentazione di 18 mesi – a partire dall’1 luglio – per la quale saranno stanziati fino a 3 milioni di euro.
Lo studio clinico, che dovrà verificare se il trattamento sia davvero efficace, è promosso dal Ministero della Salute, con la collaborazione dell’Agenzia Italiana del Farmaco e del Centro nazionale trapianti e sarà coordinato dall’Istituto Superiore di Sanità, «in deroga alla normativa vigente», ma con l’unico valvola per garantire la sicurezza dei pazienti.
La preparazione delle linee cellulari, infatti, dovrebbero avvenire in GMP (Good manufacturing practicies) e non in GLP (Good Laboratory Practice).
È stata prevista anche l’istituzione di un Osservatorio «con compiti consultivi e di proposta, di monitoraggio, di garanzia di trasparenza delle informazioni e delle procedure», formato da esperti e associazioni dei familiari dei pazienti.
La legge ha, infine, spostato al 1° aprile 2014 la chiusura degli Ospedali psichiatrici giudiziari, con deroga di un anno.
Angela Scalisi

Lascia un commento